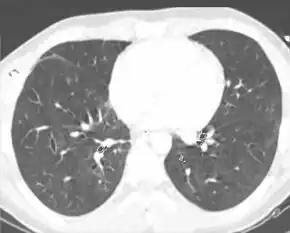

Pulmonary contusion
| Pulmonary contusion | |
|---|---|
| Other names: Lung contusion | |
![]() | |
| A CT scan showing a pulmonary contusion (red arrow) accompanied by a rib fracture (blue arrow) | |
| Specialty | Emergency medicine |
| Symptoms | Shortness of breath, coughing[1] |
| Complications | Acute respiratory distress syndrome, pneumonia, pulmonary bleeding, respiratory failure[1] |
| Usual onset | Hours to days[1] |
| Duration | 5 to 7 days[1] |
| Causes | Blunt chest trauma, explosions, penetrating injuries[1] |
| Diagnostic method | Medical imaging[1] |
| Differential diagnosis | Hemothorax, pulmonary edema including transfusion-associated lung injury[1] |
| Treatment | Supportive care[1] |
| Frequency | Common[2] |
A pulmonary contusion, also known as lung contusion, is a bruise of the lung.[1] Symptoms may include shortness of breath, chest wall tenderness, and coughing, including coughing up blood.[1][2] Onset of symptoms may occur within hours to days of the injury.[1] Complications can include acute respiratory distress syndrome, pneumonia, pulmonary bleeding, and respiratory failure.[1] Unlike lung laceration, pulmonary contusion does not involve a cut or tear of the lung tissue.[1]
It is usually caused by blunt trauma to the chest.[1] Other causes include the shock wave from an explosion or penetrating injury.[1] The underlying mechanism involves injury to the lung parenchyma, leading to leakage of fluid from the capillaries into the alveoli.[1] Diagnosis is by medical imaging such as chest X-ray, CT scan, or ultrasound.[1] Associated injuries may include rib fractures or a pneumothorax.[2]
The use of seat belts and airbags reduces the risk to people in vehicles.[3] The contusion frequently heals on its own with supportive care.[1] This may include close monitoring, supplemental oxygen, and pain medication.[1][2] If breathing is severely compromised, mechanical ventilation may be necessary.[2] Fluid replacement may be required to ensure adequate blood volume, but fluids are given carefully since fluid overload can worsen pulmonary edema.[1]
Pulmonary contusions are common, making up about 30% to 75% of lung injuries due to blunt chest injuries.[2][1] The risk of death is about 10% to 25%.[1] The condition was first described in 1761 by the Italian Morgagni.[1] With the use of explosives during World Wars I and II, pulmonary contusion from blasts gained greater recognition.[1]
Signs and symptoms
Presentation may be subtle; people with mild contusion may have no symptoms.[4] However, pulmonary contusion is frequently associated with signs (objective indications) and symptoms (subjective states), including those indicative of the lung injury itself and of accompanying injuries. Because gas exchange is impaired, signs of low blood oxygen saturation, such as low concentrations of oxygen in arterial blood gas and cyanosis (bluish color of the skin and mucous membranes) are commonly associated.[3] Dyspnea (painful breathing or difficulty breathing) is commonly seen,[3] and tolerance for exercise may be lowered.[5] Rapid breathing and a rapid heart rate are other signs.[6][7] With more severe contusions, breath sounds heard through a stethoscope may be decreased, or rales (an abnormal crackling sound in the chest accompanying breathing) may be present.[3][8] People with severe contusions may have bronchorrhea (the production of watery sputum).[9] Wheezing and coughing are other signs.[10] Coughing up blood or bloody sputum is present in up to half of cases.[10] Cardiac output (the volume of blood pumped by the heart) may be reduced,[9] and hypotension (low blood pressure) is frequently present.[3] The area of the chest wall near the contusion may be tender[11] or painful due to associated chest wall injury.
Signs and symptoms take time to develop, and as many as half of cases are asymptomatic at the initial presentation.[4] The more severe the injury, the more quickly symptoms become apparent. In severe cases, symptoms may occur as quickly as three or four hours after the trauma.[9] Hypoxemia (low oxygen concentration in the arterial blood) typically becomes progressively worse over 24–48 hours after injury.[12] In general, pulmonary contusion tends to worsen slowly over a few days,[13] but it may also cause rapid deterioration or death if untreated.[3]
Causes

Pulmonary contusion is the most common injury found in blunt chest trauma,[14] occurring in 25–35% of cases.[15] It is usually caused by the rapid deceleration that results when the moving chest strikes a fixed object.[10] About 70% of cases result from motor vehicle collisions,[16] most often when the chest strikes the inside of the car.[3] Falls,[16] assaults,[17] and sports injuries are other causes.[18] Pulmonary contusion can also be caused by explosions; the organs most vulnerable to blast injuries are those that contain gas, such as the lungs.[19] Blast lung is severe pulmonary contusion, bleeding, or edema with damage to alveoli and blood vessels, or a combination of these.[20] This is the primary cause of death among people who initially survive an explosion.[21] Unlike other mechanisms of injury in which pulmonary contusion is often found alongside other injuries, explosions can cause pulmonary contusion without damage to the chest wall.[14]
In addition to blunt trauma, penetrating trauma can cause pulmonary contusion.[22] Contusion resulting from penetration by a rapidly moving projectile usually surrounds the path along which the projectile traveled through the tissue.[23] The pressure wave forces tissue out of the way, creating a temporary cavity; the tissue readily moves back into place, but it is damaged. Pulmonary contusions that accompany gun and knife wounds are not usually severe enough to have a major effect on outcome;[24] penetrating trauma causes less widespread lung damage than does blunt trauma.[16] An exception is shotgun wounds, which can seriously damage large areas of lung tissue through a blast injury mechanism.[24]
Mechanism


The physical processes behind pulmonary contusion are poorly understood. However, it is known that lung tissue can be crushed when the chest wall bends inward on impact.[25] Three other possible mechanisms have been suggested: the inertial effect, the spalling effect, and the implosion effect.
- In the inertial effect, the lighter alveolar tissue is sheared from the heavier hilar structures, an effect similar to diffuse axonal injury in head injury.[4] It results from the fact that different tissues have different densities, and therefore different rates of acceleration or deceleration.[8]
- In the spalling effect, lung tissue bursts or is sheared where a shock wave meets the lung tissue, at interfaces between gas and liquid.[19] The alveolar walls form such a gas-liquid interface with the air in the alveoli.[4][26] The spalling effect occurs in areas with large differences in density; particles of the denser tissue are spalled (thrown) into the less dense particles.[27]
- The implosion effect occurs when a pressure wave passes through a tissue containing bubbles of gas: the bubbles first implode, then rebound and expand beyond their original volume.[28] The air bubbles cause many tiny explosions, resulting in tissue damage;[28] the overexpansion of gas bubbles stretches and tears alveoli.[29][30] This effect is thought to occur microscopically when the pressure in the airways increases sharply.[25]
Contusion usually occurs on the lung directly under the site of impact, but, as with traumatic brain injury, a contrecoup contusion may occur at the site opposite the impact as well.[23] A blow to the front of the chest may cause contusion on the back of the lungs because a shock wave travels through the chest and hits the curved back of the chest wall; this reflects the energy onto the back of the lungs, concentrating it. (A similar mechanism may occur at the front of the lungs when the back is struck.)[30]
The amount of energy transferred to the lung is determined in a large part by the compliance (flexibility) of the chest wall.[23] Children's chests are more flexible because their ribs are more elastic and there is less ossification of their intercostal cartilage.[11] Therefore, their chest walls bend, absorbing less of the force and transmitting more of it to the underlying organs.[11][31] An adult's more bony chest wall absorbs more of the force itself rather than transmitting it.[31] Thus children commonly get pulmonary contusions without fractures overlying them, while elderly people are more likely to suffer fractures than contusions.[12][23] One study found that pulmonary contusions were accompanied by fractures 62% of the time in children and 80% of the time in adults.[30]
Pulmonary contusion results in bleeding and fluid leakage into lung tissue, which can become stiffened and lose its normal elasticity. The water content of the lung increases over the first 72 hours after injury, potentially leading to frank pulmonary edema in more serious cases.[19] As a result of these and other pathological processes, pulmonary contusion progresses over time and can cause hypoxia (insufficient oxygen).
Bleeding and swelling
In contusions, torn capillaries leak fluid into the tissues around them.[32] The membrane between alveoli and capillaries is torn; damage to this capillary–alveolar membrane and small blood vessels causes blood and fluids to leak into the alveoli and the interstitial space (the space surrounding cells) of the lung.[9] With more severe trauma, there is a greater amount of edema, bleeding, and tearing of the alveoli.[16] Pulmonary contusion is characterized by microhemorrhages (tiny bleeds) that occur when the alveoli are traumatically separated from airway structures and blood vessels.[23] Blood initially collects in the interstitial space, and then edema occurs by an hour or two after injury.[29] An area of bleeding in the contused lung is commonly surrounded by an area of edema.[23] In normal gas exchange, carbon dioxide diffuses across the endothelium of the capillaries, the interstitial space, and across the alveolar epithelium; oxygen diffuses in the other direction. Fluid accumulation interferes with gas exchange,[33] and can cause the alveoli to fill with proteins and collapse due to edema and bleeding.[23] The larger the area of the injury, the more severe respiratory compromise will be.[16]
Consolidation and collapse
Pulmonary contusion can cause parts of the lung to consolidate, alveoli to collapse, and atelectasis (partial or total lung collapse) to occur.[34] Consolidation occurs when the parts of the lung that are normally filled with air fill with material from the pathological condition, such as blood.[35] Over a period of hours after the injury, the alveoli in the injured area thicken and may become consolidated.[23] A decrease in the amount of surfactant produced also contributes to the collapse and consolidation of alveoli;[15] inactivation of surfactant increases their surface tension.[30] Reduced production of surfactant can also occur in surrounding tissue that was not originally injured.[25]
Inflammation of the lungs, which can result when components of blood enter the tissue due to contusion, can also cause parts of the lung to collapse. Macrophages, neutrophils, and other inflammatory cells and blood components can enter the lung tissue and release factors that lead to inflammation, increasing the likelihood of respiratory failure.[36] In response to inflammation, excess mucus is produced, potentially plugging parts of the lung and leading to their collapse.[23] Even when only one side of the chest is injured, inflammation may also affect the other lung.[36] Uninjured lung tissue may develop edema, thickening of the septa of the alveoli, and other changes.[37] If this inflammation is severe enough, it can lead to dysfunction of the lungs like that seen in acute respiratory distress syndrome.[38]
Ventilation/perfusion mismatch
Normally, the ratio of ventilation to perfusion is about one-to-one; the volume of air entering the alveoli (ventilation) is about equal to that of blood in the capillaries around them (perfusion).[39] This ratio is reduced in pulmonary contusion; fluid-filled alveoli cannot fill with air, oxygen does not fully saturate the hemoglobin, and the blood leaves the lung without being fully oxygenated.[40] Insufficient inflation of the lungs, which can result from inadequate mechanical ventilation or an associated injury such as flail chest, can also contribute to the ventilation/perfusion mismatch.[30] As the mismatch between ventilation and perfusion grows, blood oxygen saturation is reduced.[40] Pulmonary hypoxic vasoconstriction, in which blood vessels near the hypoxic alveoli constrict (narrow their diameter) in response to the lowered oxygen levels, can occur in pulmonary contusion.[26] The vascular resistance increases in the contused part of the lung, leading to a decrease in the amount of blood that flows into it,[37] directing blood to better-ventilated areas.[26] Although reducing blood flow to the unventilated alveoli is a way to compensate for the fact that blood passing unventilated alveoli is not oxygenated,[26] the oxygenation of the blood remains lower than normal.[39] If it is severe enough, the hypoxemia resulting from fluid in the alveoli cannot be corrected just by giving supplemental oxygen; this problem is the cause of a large portion of the fatalities that result from trauma.[40]
Diagnosis
To diagnose pulmonary contusion, health professionals use clues from a physical examination, information about the event that caused the injury, and radiography.[16] Laboratory findings may also be used; for example, arterial blood gasses may show insufficient oxygen and excessive carbon dioxide even in someone receiving supplemental oxygen.[34] However, blood gas levels may show no abnormality early in the course of pulmonary contusion.[22]
X-ray

Chest X-ray is the most common method used for diagnosis,[36] and may be used to confirm a diagnosis already made using clinical signs.[19] Consolidated areas appear white on an X-ray film.[41] Contusion is not typically restricted by the anatomical boundaries of the lobes or segments of the lung.[26][42][43] The X-ray appearance of pulmonary contusion is similar to that of aspiration,[31] and the presence of hemothorax or pneumothorax may obscure the contusion on a radiograph.[24] Signs of contusion that progress after 48 hours post-injury are likely to be actually due to aspiration, pneumonia, or ARDS.[8]
Although chest radiography is an important part of the diagnosis, it is often not sensitive enough to detect the condition early after the injury.[34] In a third of cases, pulmonary contusion is not visible on the first chest radiograph performed.[5] It takes an average of six hours for the characteristic white regions to show up on a chest X-ray, and the contusion may not become apparent for 48 hours.[5][26][42] When a pulmonary contusion is apparent in an X-ray, it suggests that the trauma to the chest was severe and that a CT scan might reveal other injuries that were missed with X-ray.[44]
Computed tomography

Computed tomography (CT scanning) is a more sensitive test for pulmonary contusion,[3][32] and it can identify abdominal, chest, or other injuries that accompany the contusion.[37] In one study, chest X-ray detected pulmonary contusions in 16.3% of people with serious blunt trauma, while CT detected them in 31.2% of the same people.[45] Unlike X-ray, CT scanning can detect the contusion almost immediately after the injury.[42] However, in both X-ray and CT a contusion may become more visible over the first 24–48 hours after trauma as bleeding and edema into lung tissues progress.[46] CT scanning also helps determine the size of a contusion, which is useful in determining whether a patient needs mechanical ventilation; a larger volume of contused lung on CT scan is associated with an increased likelihood that ventilation will be needed.[42] CT scans also help differentiate between contusion and pulmonary hematoma, which may be difficult to tell apart otherwise.[47] However, pulmonary contusions that are visible on CT but not chest X-ray are usually not severe enough to affect outcome or treatment.[36]
Ultrasound
Pulmonary ultrasound, performed at the bedside or on the accident scene, is being explored as a diagnosis for pulmonary contusion. Its use is still not widespread, being limited to facilities which are comfortable with its use for other applications, like pneumothorax, airway management, and hemothorax. Accuracy has been found to be comparable to CT scanning.[48]
Classification
Pulmonary contusion and laceration are injuries to the lung tissue. Pulmonary laceration, in which lung tissue is torn or cut, differs from pulmonary contusion in that the former involves disruption of the macroscopic architecture of the lung,[49] while the latter does not.[44] When lacerations fill with blood, the result is pulmonary hematoma, a collection of blood within the lung tissue.[50] Contusion involves hemorrhage in the alveoli (tiny air-filled sacs responsible for absorbing oxygen), but a hematoma is a discrete clot of blood not interspersed with lung tissue.[13] A collapsed lung can result when the pleural cavity (the space outside the lung) accumulates blood (hemothorax) or air (pneumothorax) or both (hemopneumothorax). These conditions do not inherently involve damage to the lung tissue itself, but they may be associated with it. Injuries to the chest wall are also distinct from but may be associated with lung injuries. Chest wall injuries include rib fractures and flail chest, in which multiple ribs are broken so that a segment of the ribcage is detached from the rest of the chest wall and moves independently.
Prevention
Prevention of pulmonary contusion is similar to that of other chest trauma. Airbags in combination with seat belts can protect vehicle occupants by preventing the chest from striking the interior of the vehicle during a collision, and by distributing forces involved in the crash more evenly across the body.[3] However, in rare cases, an airbag causes pulmonary contusion in a person who is not properly positioned when it deploys.[51] Child restraints such as carseats protect children in vehicle collisions from pulmonary contusion.[52] Equipment exists for use in some sports to prevent chest and lung injury; for example, in softball the catcher is equipped with a chest protector.[53] Athletes who do not wear such equipment, such as basketball players, can be trained to protect their chests from impacts.[53] Protective garments can also prevent pulmonary contusion in explosions.[54] Although traditional body armor made from rigid plates or other heavy materials protects from projectiles generated by a blast, it does not protect against pulmonary contusion, because it does not prevent the blast's shock wave from being transferred to the lung.[54] Special body armor has been designed for military personnel at high risk for blast injuries; these garments can prevent a shock wave from being propagated across the chest wall to the lung, and thus protect wearers from blast lung injuries.[54] These garments alternate layers of materials with high and low acoustic impedance (the product of a material's density and a wave's velocity through it) in order to "decouple" the blast wave, preventing its propagation into the tissues.[54]
Treatment
No treatment is known to speed the healing of a pulmonary contusion; the main care is supportive.[38] Attempts are made to discover injuries accompanying the contusion,[19] to prevent additional injury, and to provide supportive care while waiting for the contusion to heal.[38] Monitoring, including keeping track of fluid balance, respiratory function, and oxygen saturation using pulse oximetry is also required as the patient's condition may progressively worsen.[55] Monitoring for complications such as pneumonia and acute respiratory distress syndrome is of critical importance.[56] Treatment aims to prevent respiratory failure and to ensure adequate blood oxygenation.[15][22] Supplemental oxygen can be given and it may be warmed and humidified.[40] When the contusion does not respond to other treatments, extracorporeal membranous oxygenation may be used, pumping blood from the body into a machine that oxygenates it and removes carbon dioxide prior to pumping it back in.[57]
Ventilation

Positive pressure ventilation, in which air is forced into the lungs, is needed when oxygenation is significantly impaired. Noninvasive positive pressure ventilation including continuous positive airway pressure (CPAP) and bi-level positive airway pressure (BiPAP), may be used to improve oxygenation and treat atelectasis: air is blown into the airways at a prescribed pressure via a face mask.[38] Noninvasive ventilation has advantages over invasive methods because it does not carry the risk of infection that intubation does, and it allows normal coughing, swallowing, and speech.[38] However, the technique may cause complications; it may force air into the stomach or cause aspiration of stomach contents, especially when level of consciousness is decreased.[13]
People with signs of inadequate respiration or oxygenation may need to be intubated[5] and mechanically ventilated.[10] Mechanical ventilation aims to reduce pulmonary edema and increase oxygenation.[26] Ventilation can reopen collapsed alveoli, but it is harmful for them to be repeatedly opened, and positive pressure ventilation can also damage the lung by overinflating it.[58] Intubation is normally reserved for when respiratory problems occur,[5] but most significant contusions do require intubation, and it may be done early in anticipation of this need.[13] People with pulmonary contusion who are especially likely to need ventilation include those with prior severe lung disease or kidney problems; the elderly; those with a lowered level of consciousness; those with low blood oxygen or high carbon dioxide levels; and those who will undergo operations with anesthesia.[40] Larger contusions have been correlated with a need for ventilation for longer periods of time.[14]
Pulmonary contusion or its complications such as acute respiratory distress syndrome may cause lungs to lose compliance (stiffen), so higher pressures may be needed to give normal amounts of air[13] and oxygenate the blood adequately.[32] Positive end-expiratory pressure (PEEP), which delivers air at a given pressure at the end of the expiratory cycle, can reduce edema and keep alveoli from collapsing.[11] PEEP is considered necessary with mechanical ventilation; however, if the pressure is too great it can expand the size of the contusion[16] and injure the lung.[38] When the compliance of the injured lung differs significantly from that of the uninjured one, the lungs can be ventilated independently with two ventilators in order to deliver air at different pressures; this helps avoid injury from overinflation while providing adequate ventilation.[59]
Fluid therapy
The administration of fluid therapy in individuals with pulmonary contusion is controversial.[40] Excessive fluid in the circulatory system (hypervolemia) can worsen hypoxia because it can cause fluid leakage from injured capillaries (pulmonary edema), which are more permeable than normal.[30][42] However, low blood volume (hypovolemia) resulting from insufficient fluid has an even worse impact, potentially causing hypovolemic shock; for people who have lost large amounts of blood, fluid resuscitation is necessary.[40] A lot of the evidence supporting the idea that fluids should be withheld from people with pulmonary contusion came from animal studies, not clinical trials with humans; human studies have had conflicting findings on whether fluid resuscitation worsens the condition.[19] Current recommendations suggest giving enough fluid to ensure sufficient blood flow but not giving any more fluid than necessary.[14] For people who do require large amounts of intravenous fluid, a catheter may be placed in the pulmonary artery to measure the pressure within it.[3] Measuring pulmonary artery pressure allows the clinician to give enough fluids to prevent shock without exacerbating edema.[60] Diuretics, drugs that increase urine output to reduce excessive fluid in the system, can be used when fluid overload does occur, as long as there is not a significant risk of shock.[14] Furosemide, a diuretic used in the treatment of pulmonary contusion, also relaxes the smooth muscle in the veins of the lungs, thereby decreasing pulmonary venous resistance and reducing the pressure in the pulmonary capillaries.[42]
Supportive care
Retaining secretions in the airways can worsen hypoxia[61] and lead to infections.[13] Thus, an important part of treatment is pulmonary toilet, the use of suction, deep breathing, coughing, and other methods to remove material such as mucus and blood from the airways.[5] Chest physical therapy makes use of techniques such as breathing exercises, stimulation of coughing, suctioning, percussion, movement, vibration, and drainage to rid the lungs of secretions, increase oxygenation, and expand collapsed parts of the lungs.[62] People with pulmonary contusion, especially those who do not respond well to other treatments, may be positioned with the uninjured lung lower than the injured one to improve oxygenation.[42] Inadequate pulmonary toilet can result in pneumonia.[39] People who do develop infections are given antibiotics.[16] No studies have yet shown a benefit of using antibiotics as a preventative measure before infection occurs, although some doctors do recommend prophylactic antibiotic use even without scientific evidence of its benefit.[11] However, this can cause the development of antibiotic resistant strains of bacteria, so giving antibiotics without a clear need is normally discouraged.[19] For people who are at especially high risk of developing infections, the sputum can be cultured to test for the presence of infection-causing bacteria; when they are present, antibiotics are used.[26]
Pain control is another means to facilitate the elimination of secretions. A chest wall injury can make coughing painful, increasing the likelihood that secretions will accumulate in the airways.[63] Chest injuries also contribute to hypoventilation (inadequate breathing) because the chest wall movement involved in breathing adequately is painful.[63][64] Insufficient expansion of the chest may lead to atelectasis, further reducing oxygenation of the blood.[34] Analgesics (pain medications) can be given to reduce pain.[10] Injection of anesthetics into nerves in the chest wall, called nerve blockade, is another approach to pain management; this does not depress respiration the way some pain medications can.[30]
Prognosis
Pulmonary contusion usually resolves itself[22] without causing permanent complications;[49] however it may also have long-term ill effects on respiratory function.[37][66] Most contusions resolve in five to seven days after the injury.[49] Signs detectable by radiography are usually gone within 10 days after the injury—when they are not, other conditions, such as pneumonia, are the likely cause.[26] Chronic lung disease correlates with the size of the contusion and can interfere with an individual's ability to return to work.[23] Fibrosis of the lungs can occur, resulting in dyspnea (shortness of breath), low blood oxygenation, and reduced functional residual capacity for as long as six years after the injury.[37] As late as four years post-injury, decreased functional residual capacity has been found in most pulmonary contusion patients studied.[42] During the six months after pulmonary contusion, up to 90% of people suffer difficulty breathing.[26][42] In some cases, dyspnea persists for an indefinite period.[5] Contusion can also permanently reduce the compliance of the lungs.[67]
Complications

Pulmonary contusion can result in respiratory failure—about half of such cases occur within a few hours of the initial trauma.[42] Other severe complications, including infections and acute respiratory distress syndrome (ARDS) occur in up to half of cases.[30] Elderly people and those who have heart, lung, or kidney disease prior to the injury are more likely to stay longer in hospital and have complications from the injury. Complications occur in 55% of people with heart or lung disease and 13% of those without.[36] Of people with pulmonary contusion alone, 17% develop ARDS, while 78% of people with at least two additional injuries develop the condition.[3] A larger contusion is associated with an increased risk. In one study, 82% of people with 20% or more of the lung volume affected developed ARDS, while only 22% of people with less than 20% did so.[5]
Pneumonia, another potential complication, develops in as many as 20% of people with pulmonary contusion.[11] Contused lungs are less able to remove bacteria than uninjured lungs, predisposing them to infection.[68] Intubation and mechanical ventilation further increase the risk of developing pneumonia; the tube is passed through the nose or mouth into the airways, potentially tracking bacteria from the mouth or sinuses into them.[38] Also, intubation prevents coughing, which would clear bacteria-laden secretions from the airways, and secretions pool near the tube's cuff and allow bacteria to grow.[38] The sooner the endotracheal tube is removed, the lower the risk of pneumonia, but if it is removed too early and has to be put back in, the risk of pneumonia rises.[38] People who are at risk for pulmonary aspiration (e.g. those with lowered level of consciousness due to head injuries) are especially likely to get pneumonia.[38] As with ARDS, the chances of developing pneumonia increase with the size of the contusion.[5] Children and adults have been found to have similar rates of complication with pneumonia and ARDS.[30]
Associated injuries

A large amount of force is required to cause pulmonary contusion; a person injured with such force is likely to have other types of injuries as well.[22] In fact, pulmonary contusion can be used to gauge the severity of trauma.[24] Up to three quarters of cases are accompanied by other chest injuries,[38] the most common of these being hemothorax and pneumothorax.[36] Flail chest is usually associated with significant pulmonary contusion,[14] and the contusion, rather than the chest wall injury, is often the main cause of respiratory failure in people with these injuries.[70] Other indications of thoracic trauma may be associated, including fracture of the sternum and bruising of the chest wall.[64] Over half of fractures of the scapula are associated with pulmonary contusion.[26] The contusion is frequently found underlying fracture sites.[34] When accompanied by a fracture, it is usually concentrated into a specific location—the contusion is more diffuse when there is no fracture.[30][42] Pulmonary lacerations may result from the same blunt or penetrating forces that cause contusion.[71] Lacerations can result in pulmonary hematomas; these are reported to develop in 4–11% of pulmonary contusions.[71]
Epidemiology
Pulmonary contusion is found in 30–75% of severe cases of chest injury, making it the most common serious injury to occur in association with thoracic trauma.[3] Of people who have multiple injuries with an injury severity score of over 15, pulmonary contusion occurs in about 17%.[19] It is difficult to determine the death rate (mortality) because pulmonary contusion rarely occurs by itself.[16] Usually, deaths of people with pulmonary contusion result from other injuries, commonly traumatic brain injury.[23] It is controversial whether pulmonary contusion with flail chest is a major factor in mortality on its own or whether it merely contributes to mortality in people with multiple injuries.[72] The estimated mortality rate of pulmonary contusion ranges from 14–40%, depending on the severity of the contusion itself and on associated injuries.[9] When the contusions are small, they do not normally increase the chance of death or poor outcome for people with blunt chest trauma; however, these chances increase with the size of the contusion.[36] One study found that 35% of people with multiple significant injuries including pulmonary contusion die.[16] In another study, 11% of people with pulmonary contusion alone died, while the number rose to 22% in those with additional injuries.[3] Pulmonary contusion is thought to be the direct cause of death in a quarter to a half of people with multiple injuries (polytrauma) who die.[73] An accompanying flail chest increases the morbidity and mortality to more than twice that of pulmonary contusion alone.[42]
Pulmonary contusion is the most common cause of death among vehicle occupants involved in accidents,[74] and it is thought to contribute significantly in about a quarter of deaths resulting from vehicle collisions.[24] As vehicle use has increased, so has the number of auto accidents, and with it the number of chest injuries.[38] However an increase in the number of airbags installed in modern cars may be decreasing the incidence of pulmonary contusion.[3] Use of child restraint systems has brought the approximate incidence of pulmonary contusion in children in vehicle accidents from 22% to 10%.[52]
Differences in the bodies of children and adults lead to different manifestations of pulmonary contusion and associated injuries; for example, children have less body mass, so the same force is more likely to lead to trauma in multiple body systems.[30] Since their chest walls are more flexible, children are more vulnerable to pulmonary contusion than adults are,[22] and thus suffer from the injury more commonly.[29] Pulmonary contusion has been found in 53% of children with chest injuries requiring hospitalization.[75] Children in forceful impacts suffer twice as many pulmonary contusions as adults with similar injury mechanisms, yet have proportionately fewer rib fractures.[11] The rates of certain types of injury mechanisms differ between children and adults; for example, children are more often hit by cars as pedestrians.[30] Some differences in children's physiology might be advantageous (for example they are less likely to have other medical conditions), and thus they have been predicted to have a better outcome.[76] However, despite these differences, children with pulmonary contusion have similar mortality rates to adults.[30]
History

In 1761, the Italian anatomist Giovanni Battista Morgagni was first to describe a lung injury that was not accompanied by injury to the chest wall overlying it.[19] Nonetheless, it was the French military surgeon Guillaume Dupuytren who is thought to have coined the term pulmonary contusion in the 19th century.[73] It still was not until the early 20th century that pulmonary contusion and its clinical significance began to receive wide recognition.[72] With the use of explosives during World War I came many casualties with no external signs of chest injury but with significant bleeding in the lungs.[72] Studies of World War I injuries by D.R. Hooker showed that pulmonary contusion was an important part of the concussive injury that results from explosions.[72]
Pulmonary contusion received further attention during World War II, when the bombings of Britain caused blast injuries and associated respiratory problems in both soldiers and civilians.[19] Also during this time, studies with animals placed at varying distances from a blast showed that protective gear could prevent lung injuries.[66] These findings suggested that an impact to the outside of the chest wall was responsible for the internal lesions.[66] In 1945, studies identified a phenomenon termed "wet lung", in which the lungs accumulated fluid and were simultaneously less able to remove it.[19][77] They attributed the respiratory failure often seen in blunt chest trauma in part to excessive fluid resuscitation, and the question of whether and how much to administer fluids has remained controversial ever since.[19]
During the Vietnam War, combat again provided the opportunity for study of pulmonary contusion; research during this conflict played an important role in the development of the modern understanding of its treatment.[19] The condition also began to be more widely recognized in a non-combat context in the 1960s, and symptoms and typical findings with imaging techniques such as X-ray were described.[19] Before the 1960s, it was believed that the respiratory insufficiency seen in flail chest was due to "paradoxical motion" of the flail segment of the chest wall (the flail segment moves in the opposite direction as the chest wall during respiration), so treatment was aimed at managing the chest wall injury, not the pulmonary contusion.[57] For example, positive pressure ventilation was used to stabilize the flail segment from within the chest.[14][38] It was first proposed in 1965 that this respiratory insufficiency is most often due to injury of the lung rather than to the chest wall,[19] and a group led by J.K. Trinkle confirmed this hypothesis in 1975.[37] Hence the modern treatment prioritizes the management of pulmonary contusion.[72] Animal studies performed in the late 1960s and 1970s shed light on the pathophysiological processes involved in pulmonary contusion.[66] Studies in the 1990s revealed a link between pulmonary contusion and persistent respiratory difficulty for years after the injury in people in whom the injury coexisted with flail chest.[14] In the next decade studies demonstrated that function in contused lungs improves for years after the injury.[14]
References
- 1 2 3 4 5 6 7 8 9 10 11 12 13 14 15 16 17 18 19 20 21 22 23 24 Choudhary, S; Pasrija, D; Mendez, MD (January 2020). "Pulmonary Contusion". PMID 32644340.
{{cite journal}}: Cite journal requires|journal=(help) - 1 2 3 4 5 6 "Pulmonary Contusion - Injuries; Poisoning". Merck Manuals Professional Edition. Archived from the original on 1 December 2020. Retrieved 11 December 2020.
- 1 2 3 4 5 6 7 8 9 10 11 12 13 14 Miller DL, Mansour KA (2007). "Blunt traumatic lung injuries". Thoracic Surgery Clinics. 17 (1): 57–61. doi:10.1016/j.thorsurg.2007.03.017. PMID 17650697.
- 1 2 3 4 Costantino M, Gosselin MV, Primack SL (July 2006). "The ABC's of thoracic trauma imaging". Seminars in Roentgenology. 41 (3): 209–225. doi:10.1053/j.ro.2006.05.005. PMID 16849051.
- 1 2 3 4 5 6 7 8 9 Wanek S, Mayberry JC (January 2004). "Blunt thoracic trauma: Flail chest, pulmonary contusion, and blast injury". Critical Care Clinics. 20 (1): 71–81. doi:10.1016/S0749-0704(03)00098-8. PMID 14979330.
- ↑ Mick NW, Peters JR, Egan D, Nadel ES, Walls R, Silvers S (2006). "Chest trauma". Blueprints Emergency Medicine. Second edition. Philadelphia, PA: Lippincott Williams & Wilkins. p. 76. ISBN 1-4051-0461-9.
- ↑ Coyer F, Ramsbotham J (2004). "Respiratory health breakdown". In Chang E, Daly J, Eliott D (eds.). Pathophysiology Applied to Nursing. Marrickville, NSW: Mosby Australia. pp. 154–155. ISBN 0-7295-3743-9.
- 1 2 3 Boyd AD (1989). "Lung injuries". In Hood RM, Boyd AD, Culliford AT (eds.). Thoracic Trauma. Philadelphia: Saunders. pp. 153–155. ISBN 0-7216-2353-0.
- 1 2 3 4 5 Gavelli G, Canini R, Bertaccini P, Battista G, Bnà C, Fattori R (June 2002). "Traumatic injuries: Imaging of thoracic injuries". European Radiology. 12 (6): 1273–1294. doi:10.1007/s00330-002-1439-6. PMID 12042932. S2CID 1919039.
- 1 2 3 4 5 Yamamoto L, Schroeder C, Morley D, Beliveau C (2005). "Thoracic trauma: The deadly dozen". Critical Care Nursing Quarterly. 28 (1): 22–40. doi:10.1097/00002727-200501000-00004. PMID 15732422.
- 1 2 3 4 5 6 7 Tovar JA (2008). "The lung and pediatric trauma". Seminars in Pediatric Surgery. 17 (1): 53–59. doi:10.1053/j.sempedsurg.2007.10.008. PMID 18158142.
- 1 2 Peitzman AB, Rhoades M, Schwab CW, Yealy DM, Fabian TC (2007). The Trauma Manual: Trauma and Acute Care Surgery (Spiral Manual Series). Third Edition. Hagerstown, MD: Lippincott Williams & Wilkins. p. 223. ISBN 978-0-7817-6275-5.
- 1 2 3 4 5 6 Livingston DH, Hauser CJ (2003). "Trauma to the chest wall and lung". In Moore EE, Feliciano DV, Mattox KL (eds.). Trauma. Fifth Edition. McGraw-Hill Professional. pp. 525–528. ISBN 0-07-137069-2.
- 1 2 3 4 5 6 7 8 9 Simon B, Ebert J, Bokhari F, Capella J, Emhoff T, Hayward T, et al. (November 2012). "Management of pulmonary contusion and flail chest: an Eastern Association for the Surgery of Trauma practice management guideline". The Journal of Trauma and Acute Care Surgery. 73 (5 Suppl 4): S351-61. doi:10.1097/TA.0b013e31827019fd. PMID 23114493.
- 1 2 3 Moloney JT, Fowler SJ, Chang W (February 2008). "Anesthetic management of thoracic trauma". Current Opinion in Anesthesiology. 21 (1): 41–46. doi:10.1097/ACO.0b013e3282f2aadc. PMID 18195608. S2CID 39075971.
- 1 2 3 4 5 6 7 8 9 10 Ullman EA, Donley LP, Brady WJ (2003). "Pulmonary trauma emergency department evaluation and management". Emergency Medicine Clinics of North America. 21 (2): 291–313. doi:10.1016/S0733-8627(03)00016-6. PMID 12793615.
- ↑ Haley K, Schenkel K (2003). "Thoracic trauma". In Thomas DO, Bernardo LM, Herman B (eds.). Core curriculum for pediatric emergency nursing. Sudbury, Mass: Jones and Bartlett Publishers. pp. 446. ISBN 0-7637-0176-9.
- ↑ France R (2003). "The chest and abdomen". Introduction to Sports Medicine and Athletic Training. Thomson Delmar Learning. pp. 506–507. ISBN 1-4018-1199-X.
- 1 2 3 4 5 6 7 8 9 10 11 12 13 14 15 Cohn SM (1997). "Pulmonary contusion: Review of the clinical entity". Journal of Trauma. 42 (5): 973–979. doi:10.1097/00005373-199705000-00033. PMID 9191684.
- ↑ Sasser SM, Sattin RW, Hunt RC, Krohmer J (2006). "Blast lung injury". Prehospital Emergency Care. 10 (2): 165–72. doi:10.1080/10903120500540912. PMID 16531371. S2CID 2912045.
- ↑ Born CT (2005). "Blast trauma: The fourth weapon of mass destruction" (PDF). Scandinavian Journal of Surgery. 94 (4): 279–285. doi:10.1177/145749690509400406. PMID 16425623. S2CID 44680290. Archived from the original (PDF) on 25 February 2009.
- 1 2 3 4 5 6 Lucid WA, Taylor TB (2002). "Thoracic trauma". In Strange GR (ed.). Pediatric Emergency Medicine: A Comprehensive Study Guide. New York: McGraw-Hill, Medical Publishing Division. pp. 92–100. ISBN 0-07-136979-1.
- 1 2 3 4 5 6 7 8 9 10 11 Sattler S, Maier RV (2002). "Pulmonary contusion". In Karmy-Jones R, Nathens A, Stern EJ (eds.). Thoracic Trauma and Critical Care. Berlin: Springer. pp. 159–160 and 235–243. ISBN 1-4020-7215-5.
- 1 2 3 4 5 Stern EJ, White C (1999). Chest Radiology Companion. Hagerstown, MD: Lippincott Williams & Wilkins. p. 80. ISBN 0-397-51732-7.
- 1 2 3 Hwang JC, Hanowell LH, Grande CM (1996). "Peri-operative concerns in thoracic trauma". Baillière's Clinical Anaesthesiology. 10 (1): 123–153. doi:10.1016/S0950-3501(96)80009-2.
- 1 2 3 4 5 6 7 8 9 10 11 Allen GS, Coates NE (November 1996). "Pulmonary contusion: A collective review". The American Surgeon. 62 (11): 895–900. PMID 8895709.
- ↑ Maxson TR (2002). "Management of pediatric trauma: Blast victims in a mass casualty incident". Clinical Pediatric Emergency Medicine. 3 (4): 256–261. doi:10.1016/S1522-8401(02)90038-8.
- 1 2 Bridges EJ (September 2006). "Blast injuries: From triage to critical care". Critical Care Nursing Clinics of North America. 18 (3): 333–348. doi:10.1016/j.ccell.2006.05.005. PMID 16962455.
- 1 2 3 Matthay RA, George RB, Light RJ, Matthay MA, eds. (2005). "Thoracic trauma, surgery, and perioperative management". Chest Medicine: Essentials of Pulmonary and Critical Care Medicine. Hagerstown, MD: Lippincott Williams & Wilkins. p. 578. ISBN 0-7817-5273-6.
- 1 2 3 4 5 6 7 8 9 10 11 12 13 Allen GS, Cox CS (December 1998). "Pulmonary contusion in children: Diagnosis and management". Southern Medical Journal. 91 (12): 1099–1106. doi:10.1097/00007611-199812000-00002. PMID 9853720. S2CID 28583201.
- 1 2 3 Sartorelli KH, Vane DW (May 2004). "The diagnosis and management of children with blunt injury of the chest". Seminars in Pediatric Surgery. 13 (2): 98–105. doi:10.1053/j.sempedsurg.2004.01.005. PMID 15362279.
- 1 2 3 Fleisher GR, Ludwig S, Henretig FM, Ruddy RM, Silverman BK, eds. (2006). "Thoracic trauma". Textbook of Pediatric Emergency Medicine. Hagerstown, MD: Lippincott Williams & Wilkins. pp. 1434–1441. ISBN 0-7817-5074-1.
- ↑ Bailey BJ, Johnson JT, Newlands SD, Calhoun KS, Deskin RW (2006). Head and Neck Surgery—Otolaryngology. Hagerstown, MD: Lippincott Williams & Wilkins. p. 929. ISBN 0-7817-5561-1.
- 1 2 3 4 5 Keough V, Pudelek B (2001). "Blunt chest trauma: Review of selected pulmonary injuries focusing on pulmonary contusion". AACN Clinical Issues. 12 (2): 270–281. doi:10.1097/00044067-200105000-00010. PMID 11759554.
- ↑ Collins CD, Hansell DM (1998). "Thoracic imaging". In Pryor JA, Webber BR (eds.). Physiotherapy for Respiratory and Cardiac Problems. Edinburgh: Churchill Livingstone. pp. 35. ISBN 0-443-05841-5.
- 1 2 3 4 5 6 7 Klein Y, Cohn SM, Proctor KG (February 2002). "Lung contusion: Pathophysiology and management". Current Opinion in Anesthesiology. 15 (1): 65–68. doi:10.1097/00001503-200202000-00010. PMID 17019186. S2CID 34262617. Archived from the original (PDF) on 25 February 2009.
- 1 2 3 4 5 6 Bastos R, Calhoon JH, Baisden CE (2008). "Flail chest and pulmonary contusion". Seminars in Thoracic and Cardiovascular Surgery. 20 (1): 39–45. doi:10.1053/j.semtcvs.2008.01.004. PMID 18420125.
- 1 2 3 4 5 6 7 8 9 10 11 12 13 Sutyak JP, Wohltmann CD, Larson J (2007). "Pulmonary contusions and critical care management in thoracic trauma". Thoracic Surgical Clinics. 17 (1): 11–23. doi:10.1016/j.thorsurg.2007.02.001. PMID 17650693.
- 1 2 3 Prentice D, Ahrens T (August 1994). "Pulmonary complications of trauma". Critical Care Nursing Quarterly. 17 (2): 24–33. doi:10.1097/00002727-199408000-00004. PMID 8055358. S2CID 29662985.
- 1 2 3 4 5 6 7 Kishen R, Lomas G (2003). "Thoracic trauma". In Gwinnutt CL, Driscoll P (eds.). Trauma Resuscitation: The Team Approach. Informa Healthcare. pp. 55–64. ISBN 1-85996-009-X.
- ↑ Fish RM (2003). "Diagnosis and treatment of blast injury". In Fish RM, Geddes LA, Babbs CF (eds.). Medical and Bioengineering Aspects of Electrical Injuries. Tucson, AZ: Lawyers & Judges Publishing. p. 55. ISBN 1-930056-08-7.
- 1 2 3 4 5 6 7 8 9 10 11 12 Johnson SB (2008). "Tracheobronchial injury". Seminars in Thoracic and Cardiovascular Surgery. 20 (1): 52–57. doi:10.1053/j.semtcvs.2007.09.001. PMID 18420127.
- ↑ Donnelly LF (2002). "CT of Acute pulmonary infection/trauma". In Strife JL, Lucaya J (eds.). Pediatric Chest Imaging: Chest Imaging in Infants and Children. Berlin: Springer. p. 123. ISBN 3-540-43557-3.
- 1 2 Wicky S, Wintermark M, Schnyder P, Capasso P, Denys A (2000). "Imaging of blunt chest trauma". European Radiology. 10 (10): 1524–1538. doi:10.1007/s003300000435. PMID 11044920. S2CID 22311233.
- ↑ Keel M, Meier C (December 2007). "Chest injuries — what is new?". Current Opinion in Critical Care. 13 (6): 674–679. doi:10.1097/MCC.0b013e3282f1fe71. PMID 17975389. S2CID 19317500.
- ↑ Miller LA (March 2006). "Chest wall, lung, and pleural space trauma". Radiologic Clinics of North America. 44 (2): 213–224, viii. doi:10.1016/j.rcl.2005.10.006. PMID 16500204.
- ↑ Grueber GM, Prabhakar G, Shields TW (2005). "Blunt and penetrating injuries of the chest wall, pleura, and lungs". In Shields TW (ed.). General Thoracic Surgery. Philadelphia, PA: Lippincott Williams & Wilkins. p. 959. ISBN 0-7817-3889-X.
- ↑ Soldati G, Testa A, Silva F (2006). "Chest Ultrasonography in Pulmonary Contusion". Chest. 130 (2): 533–538. doi:10.1378/chest.130.2.533. PMID 16899855. Archived from the original on 3 May 2007.
- 1 2 3 Collins J, Stern EJ (2007). Chest Radiology: The Essentials. Lippincott Williams & Wilkins. p. 120. ISBN 978-0-7817-6314-1.
- ↑ Stern EJ, White C (1999). Chest Radiology Companion. Hagerstown, MD: Lippincott Williams & Wilkins. p. 103. ISBN 0-397-51732-7.
- ↑ Caudle JM, Hawkes R, Howes DW, Brison RJ (November 2007). "Airbag pneumonitis: A report and discussion of a new clinical entity". CJEM. 9 (6): 470–473. doi:10.1017/s1481803500015542. PMID 18072996.
- 1 2 Cullen ML (March 2001). "Pulmonary and respiratory complications of pediatric trauma". Respiratory Care Clinics of North America. 7 (1): 59–77. doi:10.1016/S1078-5337(05)70023-X. PMID 11584805.
- 1 2 Pfeiffer RP, Mangus BC (2007). Concepts of Athletic Training. Boston: Jones and Bartlett Publishers. pp. 200. ISBN 978-0-7637-4949-1.
- 1 2 3 4 Cooper GJ (March 1996). "Protection of the lung from blast overpressure by thoracic stress wave decouplers". Journal of Trauma. 40 (Supplement 3): S105–110. doi:10.1097/00005373-199603001-00024. PMID 8606389.
- ↑ Ridley SC (1998). "Surgery for adults". In Pryor JA, Webber BR (eds.). Physiotherapy for Respiratory and Cardiac Problems. Edinburgh: Churchill Livingstone. pp. 316. ISBN 0-443-05841-5.
- ↑ Ruddy RM (March 2005). "Trauma and the paediatric lung". Paediatric Respiratory Reviews. 6 (1): 61–67. doi:10.1016/j.prrv.2004.11.006. PMID 15698818.
- 1 2 Pettiford BL, Luketich JD, Landreneau RJ (February 2007). "The management of flail chest". Thoracic Surgery Clinics. 17 (1): 25–33. doi:10.1016/j.thorsurg.2007.02.005. PMID 17650694.
- ↑ Dueck R (December 2006). "Alveolar recruitment versus hyperinflation: A balancing act". Current Opinion in Anesthesiology. 19 (6): 650–654. doi:10.1097/ACO.0b013e328011015d. PMID 17093370. S2CID 41312348.
- ↑ Anantham D, Jagadesan R, Tiew PE (2005). "Clinical review: Independent lung ventilation in critical care". Critical Care. 9 (6): 594–600. doi:10.1186/cc3827. PMC 1414047. PMID 16356244.
- ↑ Smith M, Ball V (1998). "Thoracic trauma". Cardiovascular/respiratory physiotherapy. St. Louis: Mosby. p. 221. ISBN 0-7234-2595-7.
- ↑ Danne PD, Hunter M, MacKillop AD (2003). "Airway control". In Moore EE, Feliciano DV, Mattox KL (eds.). Trauma. Fifth Edition. McGraw-Hill Professional. p. 183. ISBN 0-07-137069-2.
- ↑ Ciesla ND (June 1996). "Chest physical therapy for patients in the intensive care unit" (PDF). Physical Therapy. 76 (6): 609–625. doi:10.1093/ptj/76.6.609. PMID 8650276. Archived (PDF) from the original on 17 May 2020.
- 1 2 Livingston DH, Hauser CJ (2003). "Trauma to the chest wall and lung". In Moore EE, Feliciano DV, Mattox KL (eds.). Trauma. Fifth Edition. McGraw-Hill Professional. p. 515. ISBN 0-07-137069-2.
- 1 2 Dolich MO, Chipman JG (2006). "Trauma". In Lawrence P, Bell RH, Dayton MT, Mohammed MA (eds.). Essentials of General Surgery. Hagerstown, MD: Lippincott Williams & Wilkins. pp. 191–192. ISBN 0-7817-5003-2.
- ↑ Le Guen M, Beigelman C, Bouhemad B, Wenjïe Y, Marmion F, Rouby JJ (2007). "Chest computed tomography with multiplanar reformatted images for diagnosing traumatic bronchial rupture: A case report". Critical Care. 11 (5): R94. doi:10.1186/cc6109. PMC 2556736. PMID 17767714.
- 1 2 3 4 Cohn SM, Zieg PM (September 1996). "Experimental pulmonary contusion: Review of the literature and description of a new porcine model". Journal of Trauma. 41 (3): 565–571. doi:10.1097/00005373-199609000-00036. PMID 8810987.
- ↑ Heck HA, Levitzky MG (2007). "The respiratory system". In O'Leary JP, Tabuenca A, Capote LR (eds.). The Physiologic Basis of Surgery. Hagerstown, MD: Lippincott Williams & Wilkins. p. 463. ISBN 978-0-7817-7138-2.
- ↑ Fry DE (2007). "Surgical infection". In O'Leary JP, Tabuenca A, Capote LR (eds.). The Physiologic Basis of Surgery. Hagerstown, MD: Lippincott Williams & Wilkins. p. 241. ISBN 978-0-7817-7138-2.
- ↑ Konijn AJ, Egbers PH, Kuiper MA (2008). "Pneumopericardium should be considered with electrocardiogram changes after blunt chest trauma: a case report". J Med Case Rep. 2 (1): 100. doi:10.1186/1752-1947-2-100. PMC 2323010. PMID 18394149.
- ↑ Hemmila MR, Wahl WL (2005). "Management of the injured patient". In Doherty GM (ed.). Current Surgical Diagnosis and Treatment. McGraw-Hill Medical. p. 214. ISBN 0-07-142315-X.
- 1 2
- 1 2 3 4 5 EAST practice management workgroup for pulmonary contusion — flail chest: Simon B, Ebert J, Bokhari F, Capella J, Emhoff T, Hayward T; et al. (2006). "Practice management guide for Pulmonary contusion — flail chest" (PDF). The Eastern Association for the Surgery of Trauma. Archived from the original (PDF) on 25 February 2009. Retrieved 18 June 2008.
{{cite web}}: CS1 maint: multiple names: authors list (link) - 1 2 Karmy-Jones R, Jurkovich GJ (March 2004). "Blunt chest trauma". Current Problems in Surgery. 41 (3): 211–380. doi:10.1016/j.cpsurg.2003.12.004. PMID 15097979.
- ↑ Milroy CM, Clark JC (2000). "Injuries and deaths in vehicle occupants". In Mason JK, Purdue BN (eds.). The Pathology of Trauma. Arnold. p. 10. ISBN 0-340-69189-1.
- ↑ Nakayama DK, Ramenofsky ML, Rowe MI (December 1989). "Chest injuries in childhood". Annals of Surgery. 210 (6): 770–5. doi:10.1097/00000658-198912000-00013. PMC 1357870. PMID 2589889.
- ↑ Allen GS, Cox CS, Moore FA, Duke JH, Andrassy RJ (September 1997). "Pulmonary contusion: are children different?". Journal of the American College of Surgeons. 185 (3): 229–33. doi:10.1016/s1072-7515(01)00920-6. PMID 9291398.
- ↑ Burford TH, Burbank B (December 1945). "Traumatic wet lung; observations on certain physiologic fundamentals of thoracic trauma". The Journal of Thoracic Surgery. 14: 415–24. doi:10.1016/S0096-5588(20)31786-4. PMID 21008101.
External links
| Classification |
|---|
- Chest Trauma - pulmonary contusion, trauma.org
